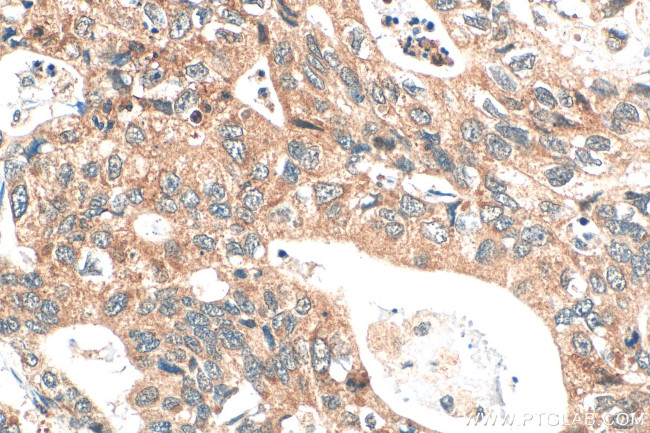
DPCR1 Antibody in Immunohistochemistry (Paraffin) (IHC (P))

Search
Proteintech
DPCR1 Polyclonal Antibody
{{$productOrderCtrl.translations['antibody.pdp.commerceCard.promotion.promotions']}}
{{$productOrderCtrl.translations['antibody.pdp.commerceCard.promotion.viewpromo']}}
{{$productOrderCtrl.translations['antibody.pdp.commerceCard.promotion.promocode']}}: {{promo.promoCode}} {{promo.promoTitle}} {{promo.promoDescription}}. {{$productOrderCtrl.translations['antibody.pdp.commerceCard.promotion.learnmore']}}
产品信息
31420-1-AP
种属反应
宿主/亚型
分类
类型
抗原
偶联物
形式
浓度
规格
纯化类型
保存液
内含物
保存条件
运输条件
产品详细信息
Immunogen sequence: DHIVLHSGQR PPELPKSTEI HEQKRHCNTT RHSKPTDKPT GNSKTIDHKS STDNHEAPPT SEENSSNQGK DPMIRNQRSV DPADSTTTHK ESAGKKHITP APKSKINCRK STTGKSTVTR KSDKTGRPLE KSMSTLDKTS TSSHKTTTSF HNSGNSQTKQ KSTSFPEKIT AASKTTYKTT GTPEESEKTE DSRTTVASDK LLTKTTKNIQ ETISANELTQ SLAEPTEHGG RTANENNTPS PAEPTENRER TANENKKTIC TKGKNTPVPE KPTENLGNTT LTTETIKAPV KSTENPEKTA AVTKTIKPSV KVTGDKSLTT TSSHLNKTEV THQVPTGSFT LITSRTKLSS ITSEATGNES HPYLNKDGSQ KGIHAGQMGE NDSFPAWA
靶标信息
The DPCR1 gene, known as diffuse panbronchiolitis critical region 1, encodes a protein involved in immune responses and epithelial cell function, particularly in the respiratory system. Although the specific functions of DPCR1 are not extensively characterized, the gene is located within a region linked to diffuse panbronchiolitis, a chronic inflammatory lung disease. DPCR1 is thought to contribute to immune regulation, potentially influencing innate immune responses and epithelial cell interactions critical for maintaining respiratory health. Its expression in airway epithelial cells suggests a role in modulating mucus production, barrier integrity, and protection against pathogens. Aberrant expression of DPCR1 may impact respiratory function, contributing to conditions such as asthma or chronic obstructive pulmonary disease (COPD) by affecting immune responses and inflammation. Understanding DPCR1's functions and regulatory mechanisms in the respiratory system is essential for exploring its potential as a therapeutic target for respiratory diseases characterized by chronic inflammation and immune dysregulation.
仅用于科研。不用于诊断过程。未经明确授权不得转售。
篇参考文献 (0)
生物信息学
蛋白别名: bCX105N19.6; diffuse panbronchiolitis critical region 1; Diffuse panbronchiolitis critical region protein 1; Diffuse panbronchiolitis critical region protein 1 homolog; MGC126710; MGC126712; Mucin-like protein 3
基因别名: C6orf37; DPCR1; Gm630; MUCL3; PBLT
UniProt ID: (Mouse) Q3TNW5, (Human) Q3MIW9
Entrez Gene ID: (Mouse) 268949, (Human) 135656